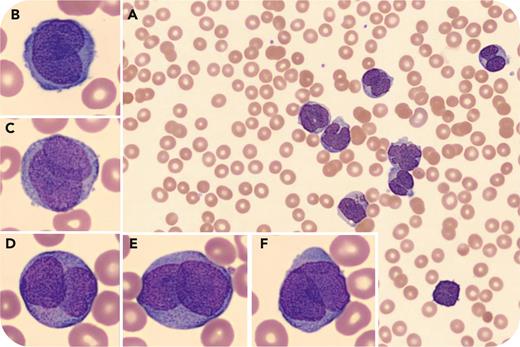
graphic

A 27-year-old woman presented with painful oral blisters and bleeding for 2 days and irregular menstrual bleeding for 3 weeks. Physical examination showed tachycardia, hemorrhagic bullae in the mouth, and scattered petechiae over the lower extremities. Blood work showed leukocytosis (86.03 × 109/L) with 81% blasts, low hemoglobin (10.3 g/dL), thrombocytopenia (11 × 109/L), hypofibrinogenemia, elevated international normalized ratio, and normal activated partial thromboplastin time and D-dimer. There was no evidence of spontaneous tumor lysis syndrome. Blood smear showed thrombocytopenia and leukocytosis with numerous large cells with bilobed and folded “dinner-plate” nuclei, a high nucleus-to-cytoplasm ratio, and hypogranular cytoplasm (panels A-F; original magnifications ×100 [A] and ×1000 [B-F], Wright stain). No Auer rods were seen. An empiric diagnosis of hypogranular acute promyelocytic leukemia (APL) was made, and all-trans retinoic acid and supportive care were started. Cytogenetics showed t(15;17), confirming APL. Despite rapid diagnosis and prompt initiation of therapy, her clinical condition deteriorated and she died of intracranial hemorrhage and brain stem herniation 4 days later.
Hypogranular APL accounts for 20% to 30% of APL cases and lacks characteristic Auer rods. The presence of the described morphologic features on smear and/or coagulopathy should raise suspicion and prompt initiation of therapy and aggressive supportive care, highlighting the importance of blood smear morphologic correlation. This is especially paramount in high-risk patients (elevated leukocyte count), whose outcome is already dismal despite appropriate therapy.
Author notes
For additional images, visit the ASH Image Bank, a reference and teaching tool that is continually updated with new atlas and case study images. For more information, visit http://imagebank.hematology.org.